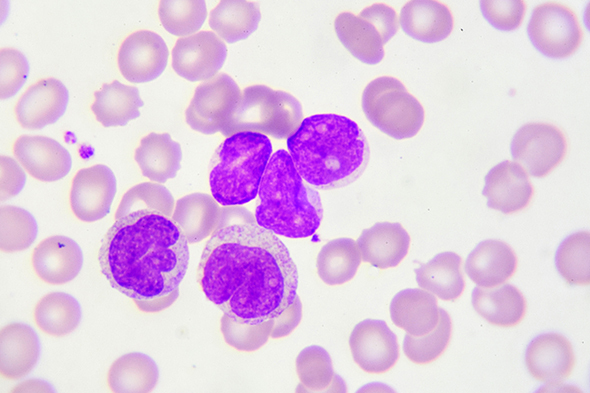
Late-line Treatment in Chronic-Phase Chronic Myeloid Leukemia

Expert Directory
Elias Jabbour, MD
Professor of Medicine, Department of Leukemia
Division of Cancer Medicine
The University of Texas MD Anderson Cancer Center
Houston, TX
Elias Jabbour, MD, is professor of medicine, Department of Leukemia, Division of Cancer Medicine, at The University of Texas MD Anderson Cancer Center in Houston. He graduated from the Saint Joseph University School of Medicine, Beirut, and joined the Hôtel-Dieu de France University Hospital as a resident. He pursued a fellowship in hematology-oncology at the Institut Gustave Roussy, France. In 2003, he joined The University of Texas MD Anderson Cancer Center as a fellow in the Department of Hematology/Leukemia and Stem Cell Transplantation. He later joined the faculty in the Department of Leukemia as an assistant professor.
Dr Jabbour is actively involved in research on both acute and chronic forms of leukemia. He was involved in clinical trials that led to the US Food and Drug Administration approvals of several drugs in chronic myeloid leukemia, myelodysplastic syndromes, and acute lymphoblastic leukemia (ALL). He actively assisted in developing chemotherapeutic and biologic agents in leukemias and contributed to the development of others. Dr Jabbour has designed more than 2 dozen clinical trials assessing new combinations for the management of de novo ALL, elderly ALL, Ph-positive ALL, and relapsed/refractory disease. Of note, he developed a protocol that has shown significant improvements in survival rates for patients with Ph-positive ALL. In addition, he developed another innovative treatment approach for these patients by combining blinatumomab, a bispecific monoclonal antibody, with ponatinib, offering a chemotherapy-free regimen that will hopefully further increase cure rates. Another area on which he focused his research is elderly patients with ALL. The aggressive biology of the disease and elderly patients’ poor tolerance of intensive chemotherapy lead to low survival rates for this patient population.
He is currently investigating an innovative strategy combining new monoclonal antibodies such as inotuzumab ozogamicin (a conjugated anti-CD22 antibody) and blinatumomab with minimal chemotherapy. If successful, such strategies will likely increase the cure rates of adult patients with ALL to the high level that is achieved in pediatric patients.
Dr Jabbour has taken an active role in the medical community, participating in numerous scientific meetings. He has authored or coauthored numerous publications (750 peer-reviewed publications) and abstracts, and serves as a reviewer for many scientific journals. He has also received several prestigious awards, including merit awards from the American Society of Clinical Oncology (2005, 2006, and 2007) and the American Society of Hematology (2005, 2006, and 2007). He has received several other honors, including the Kimberly Patterson and Shannon Timmons fellowships and the highly coveted Celgene Future Leader in Hematology (2007) and Young Investigator in Hematology (2016) awards.
Contributing Articles

Late-line Treatment in Chronic-Phase Chronic Myeloid Leukemia

Conference Reporter in Chronic Myeloid Leukemia to Cover Key Topics Being Presented at EHA2023 Hybrid Congress

Resistance and Persistence in Chronic Myeloid Leukemia

Unmet Needs in Chronic Myeloid Leukemia and Insights From Next-Generation Studies


